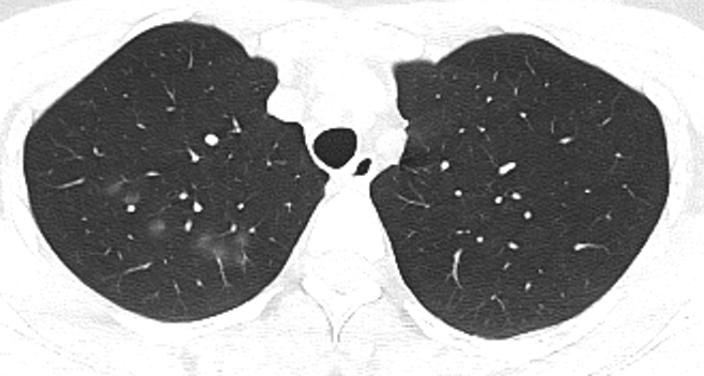
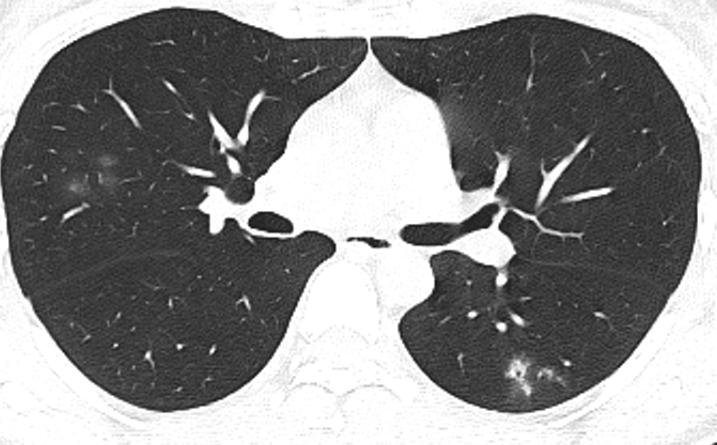
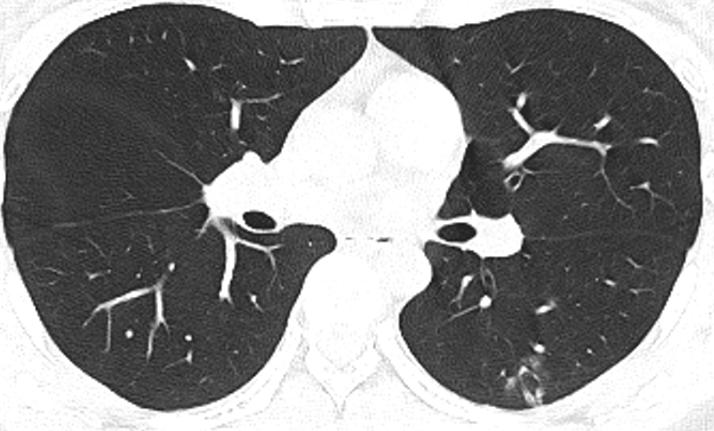
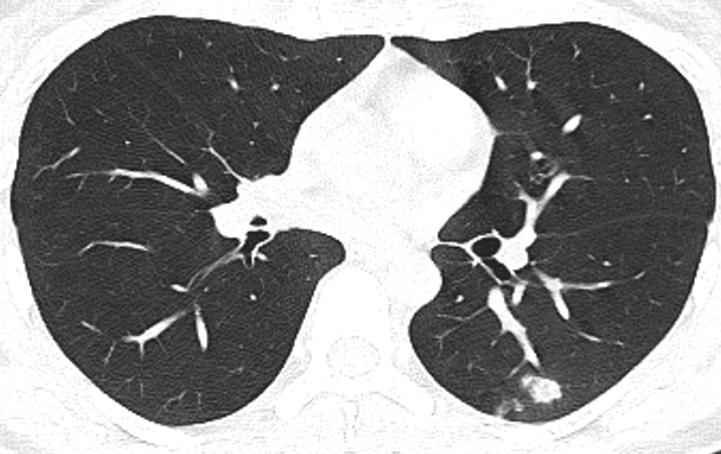
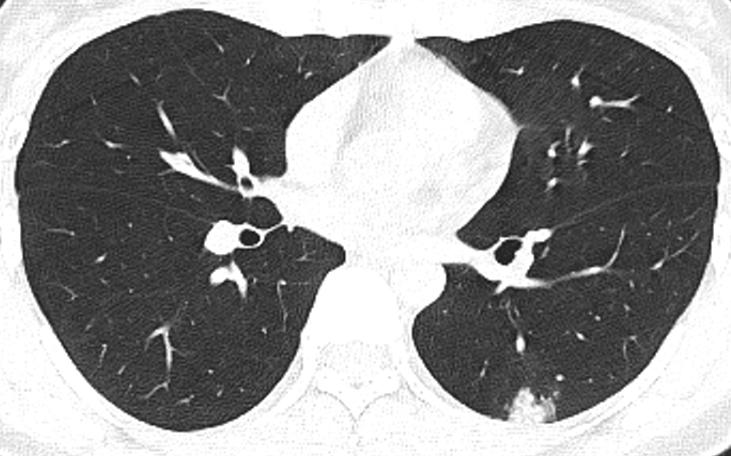

原创 孙丹雄 医学界呼吸频道
*仅供医学专业人士阅读参考
患者的初始治疗太重要了!
前言
双肺单发的磨玻璃结节一般不难,诊断方法和技术都比较成熟了,一般首先要排查肿瘤!但是,双肺多发的磨玻璃结节,很多时候反而不容易诊断,也没有相关的指南和专家共识!
今天和大家分享一例非常有趣的双肺多发磨玻璃结节!这个病例完美地诠释了早期诊断、早期规范治疗是多么的重要!
病例介绍
青年女性,平素体健,无不良嗜好。
咳嗽1年,加重2周。
1年来反复咳嗽,无明显诱因,偶尔咳少量白色粘痰,余无不适,未系统诊治。2周前咳嗽加重,咳嗽频繁,咳少量黄色、白色粘痰,无发热、咯血、胸痛、呼吸困难等不适。院外口服阿莫西林,症状无缓解。
体格检查:无异常发现。
辅助检查:血常规示嗜酸细胞稍高(9%),余无明显异常。大小便常规正常。凝血功能、血生化正常。术前传染病筛查无异常。心电图正常。
胸部CT示:双肺多发磨玻璃结节,左下叶背段散在实性结节,散在小空洞,部分支气管的管壁增厚,如下(图1~17)。

大家觉得考虑什么病可能性大?
诊治分析
1.细菌性肺炎?
肺部阴影都可能是细菌性肺炎,但细菌性肺炎很少反复咳嗽1年,且患者感染症状不明显,依据不充分。
2.支原体、衣原体肺炎?
支原体、衣原体肺炎也可能表现为双肺多发磨玻璃结节,但比较少见。
3.病毒性肺炎?
患者新冠病毒核酸阴性,无接触史,周围人群无发病,新冠病毒感染可排除,无发热亦不支持其他病毒性肺炎。
4.真菌性肺炎?
患者无免疫力低下,真菌感染的可能性微乎其微。免疫力正常人群可能感染隐球菌,但患者无鸽子接触史,隐球菌感染引起双肺多发磨玻璃结节亦很少见,依据不足。
5.肺癌?
肺癌也可能表现为双肺多发磨玻璃结节,但患者病程长,且年轻,磨玻璃结节的边界模糊,依据不足。
6.淋巴瘤?
肺淋巴瘤可表现为双肺多发磨玻璃结节,甚至双肺弥漫性磨玻璃阴影,但该病少见,目前依据不足。
7.血管炎?
肺血管炎也可表现为双肺多发磨玻璃结节,但患者无多器官损害的表现,依据不足。
8.肺结核?
患者左下叶背段散在实性结节,散在小空洞,且少数情况下肺结核也可表现为磨玻璃结节,有可能!但患者病程长,肺结核病灶应该表现为新旧不一,形态多样。
9.嗜酸细胞性肺炎?
患者双肺多发磨玻璃结节,反复咳嗽1年,血嗜酸细胞升高,有可能。
10.其他间质性肺炎?
不典型的间质性肺炎也可能表现为双肺多发磨玻璃结节,目前不能排除。
临床诊疗过程
1.血管炎不能排除,查抗中性粒细胞胞浆抗体(ANCA)阴性。
2.嗜酸细胞性肺炎不能排除,查诱导痰嗜酸细胞正常。
3.肺结核、肺癌不能排除,行支气管镜检查未见异常,左下叶背段刷检,抗酸杆菌阴性,未见癌细胞。
4.其他间质性肺炎不能排除,行肺功能检查正常,抗核抗体(ANA)阴性。
治疗:普通肺部感染也有可能,鉴于外院口服阿莫西林无效,给予头孢曲松抗感染治疗。
临床转归
头孢曲松抗感染10天后复查,病灶部分吸收,病情好转出院!

2月后复查,病灶完全吸收!

最终诊断:
细菌性肺炎
小结:
要是当初给予左氧氟沙星,或者头孢曲松联合阿奇霉素抗感染,那么这个患者不能排除支原体肺炎。要是当初加氟康唑抗真菌,那不能排除隐球菌。要是当初不抗感染,坐等化验单回报后再抗感染,那么患者的住院时间就会延长,或者焦虑的时间就会延长。要是凭感觉给予抗结核治疗,患者就会白吃结核药。要是疑诊肺癌去做肺活检就会冒不必要的风险,至于外科肺活检就更不划算。
由此可见,患者的初始治疗太重要了!初始规范使用抗生素对下一步的处理非常重要!初始治疗太乱对明确诊断干扰非常的大!事后想想,可能给予头孢曲松抗感染都太高级了,给予一代、二代头孢,可能就足够了!事后诸葛亮:假如患者经济条件不好,且对医生信任和理解,或许很多检查都不用做,先抗感染,复查后再走下一步可能会更好。
本文首发:医学界呼吸频道
本文作者:孙丹雄
原标题:《双肺多发磨玻璃结节,这个病因你知道但是想不到》